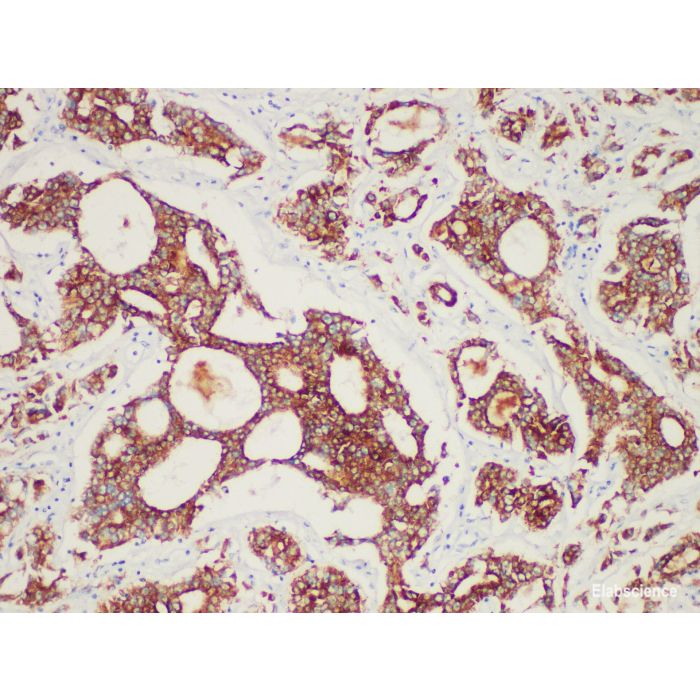
main product photo

AMACR/p504s Monoclonal Antibody
€0.00
In stock
SKU
PA6606
Catalog Number: PA6606
Isotype: Mouse, Clone: YN00066m
Reactivity: human
Applications: IHC-P
Datasheet, Questions? Contact us!
Isotype: Mouse, Clone: YN00066m
Reactivity: human
Applications: IHC-P
Datasheet, Questions? Contact us!
Background:
Alpha-methylacyl-CoA racemase (AMACR), also known as P504S, is a mitochondrial and peroxisome enzyme. AMACR is expressed in normal liver (hepatocyte), kidney (tubular epithelial cell) and gallbladder (epithelial cell). AMACR is also expressed in Lung (bronchial epithelial cells) and colon (surface epithelium of colon). AMACR is a specific marker of prostate cancer.
Location: Cytoplasm
Swissprot: Q9UHK6
Buffer: TBS with 0.1% Proclin300, PH7.4
Concentration: 100 μg/mL for the RTU antibody, 1mg/mL for the concentrated antibody
Alpha-methylacyl-CoA racemase (AMACR), also known as P504S, is a mitochondrial and peroxisome enzyme. AMACR is expressed in normal liver (hepatocyte), kidney (tubular epithelial cell) and gallbladder (epithelial cell). AMACR is also expressed in Lung (bronchial epithelial cells) and colon (surface epithelium of colon). AMACR is a specific marker of prostate cancer.
Location: Cytoplasm
Swissprot: Q9UHK6
Buffer: TBS with 0.1% Proclin300, PH7.4
Concentration: 100 μg/mL for the RTU antibody, 1mg/mL for the concentrated antibody
| Is Featured? | No |
|---|
Write Your Own Review